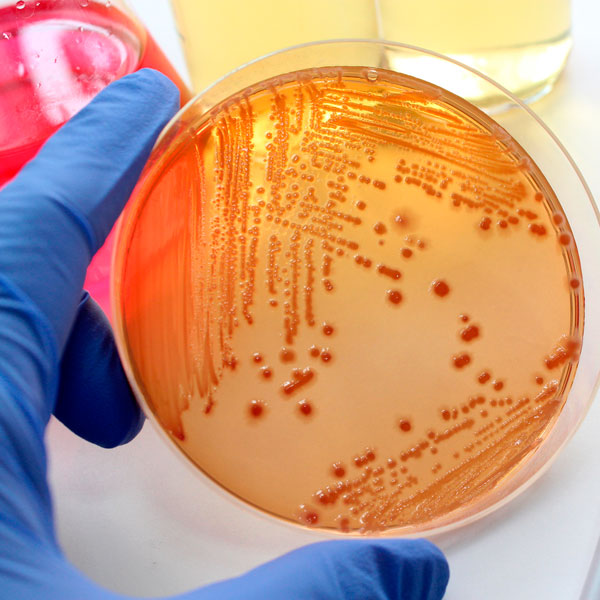
Solving bacteria problems in well water

Solving bacteria problems in well water
When bacteria show up as contamination in a water well, it indicates problems with the well construction or with the filtering soil or bedrock near where you draw your water. Bacteria can also get into a water supply if repairs to your well were made recently, or from your water treatment system. Because there are so many different causes of a bacterial contamination, seeking help from a certified water system specialist will help you identify the source of the problem faster.
What kind of bacteria are we talking about?
Total and fecal coliform bacteria, which include E. coli, grow in the intestinal track of animals and are found in sewage and animal feces. These bacteria die off within about 30 days after leaving the host. Therefore, if coliform bacteria are found in a water supply over a long period of time, it indicates continuous contamination.
Most coliform bacteria are not harmful to your health, although E. coli can cause severe illness in some, with symptoms similar to food poisoning. Their presence does indicate that other, more harmful bacteria are present and pose a health risk.
Below you’ll find a list of some of the ways bacteria can find their way into your home’s water supply.
The Cause Of Bacteria Contamination in Well Water
Poor well construction
If you have a bedrock well, bacteria contamination could be caused by a buried well head or an inadequate well cap. You can see if there are problems with the well construction by looking for leakage on the well casing after a heavy rain storm. If you have a dug well, it’s likely a problem with the casing; it leaks, it is not the right height or there is not enough backfill surrounding it. The problem can also be caused by a leaky well cover. Older wells made from fieldstone often bacteria problems as well.
Poor well construction can have a lasting effect on your water supply and could lead to other problems besides bacteria contamination. If you suspect well construction is to blame for water contamination, you should call a professional well service for a consultation.
Recent well repairs or construction
A water system should be thoroughly flushed after a new water pump, water heater or plumbing is installed in your home water system. Bacteria in the dirt surrounding the well pump or solids inside the plumbing can lead to bacterial contamination. The water should be moved quickly through the system and sometimes chlorination is required.
The installation of a new well often results in substantial bacteria entering the water system from the surrounding soil. Heavy flushing of the well usually fixes the problem, though it can take days to months to fully eliminate the bacteria.
Problems with the aquifer or surrounding soil
Bacteria in water are typically filtered out naturally as they flow through the soil, but in some cases the geology doesn’t provide an adequate filter. In dug wells, the surrounding soil may not provide the right level of filtration, leaving your water supply susceptible to repeated contamination. Treatment is an option but does not solve the underlying problem of lack of filtration. If this is the cause, it’s recommended a different type of well be installed.
If you have a bedrock well, bacteria can enter the system if the upper level of the bedrock, or the soil above the bedrock are disturbed from nearby construction or blasting. This type of contamination is usually short-lived and water quality usually goes back to normal after construction stops and the soil settles.
Contamination within your water system
Some water treatment systems, like activated carbon filters that attach to a faucet, can grow bacteria if not changed regularly. Bacteria can also form on the inside of pipes and tanks. These bacteria, as well as the mineral material formed, are called biofilm. While this is usually not a problem, sometimes biofilm will grow at a fast rate unexpectedly. Because the tests cannot tell the difference between biofilm bacteria and bacteria from other sources, it’s important to test your water after a heavy rain to see if well contamination played a factor, as opposed to contamination just from biofilm.